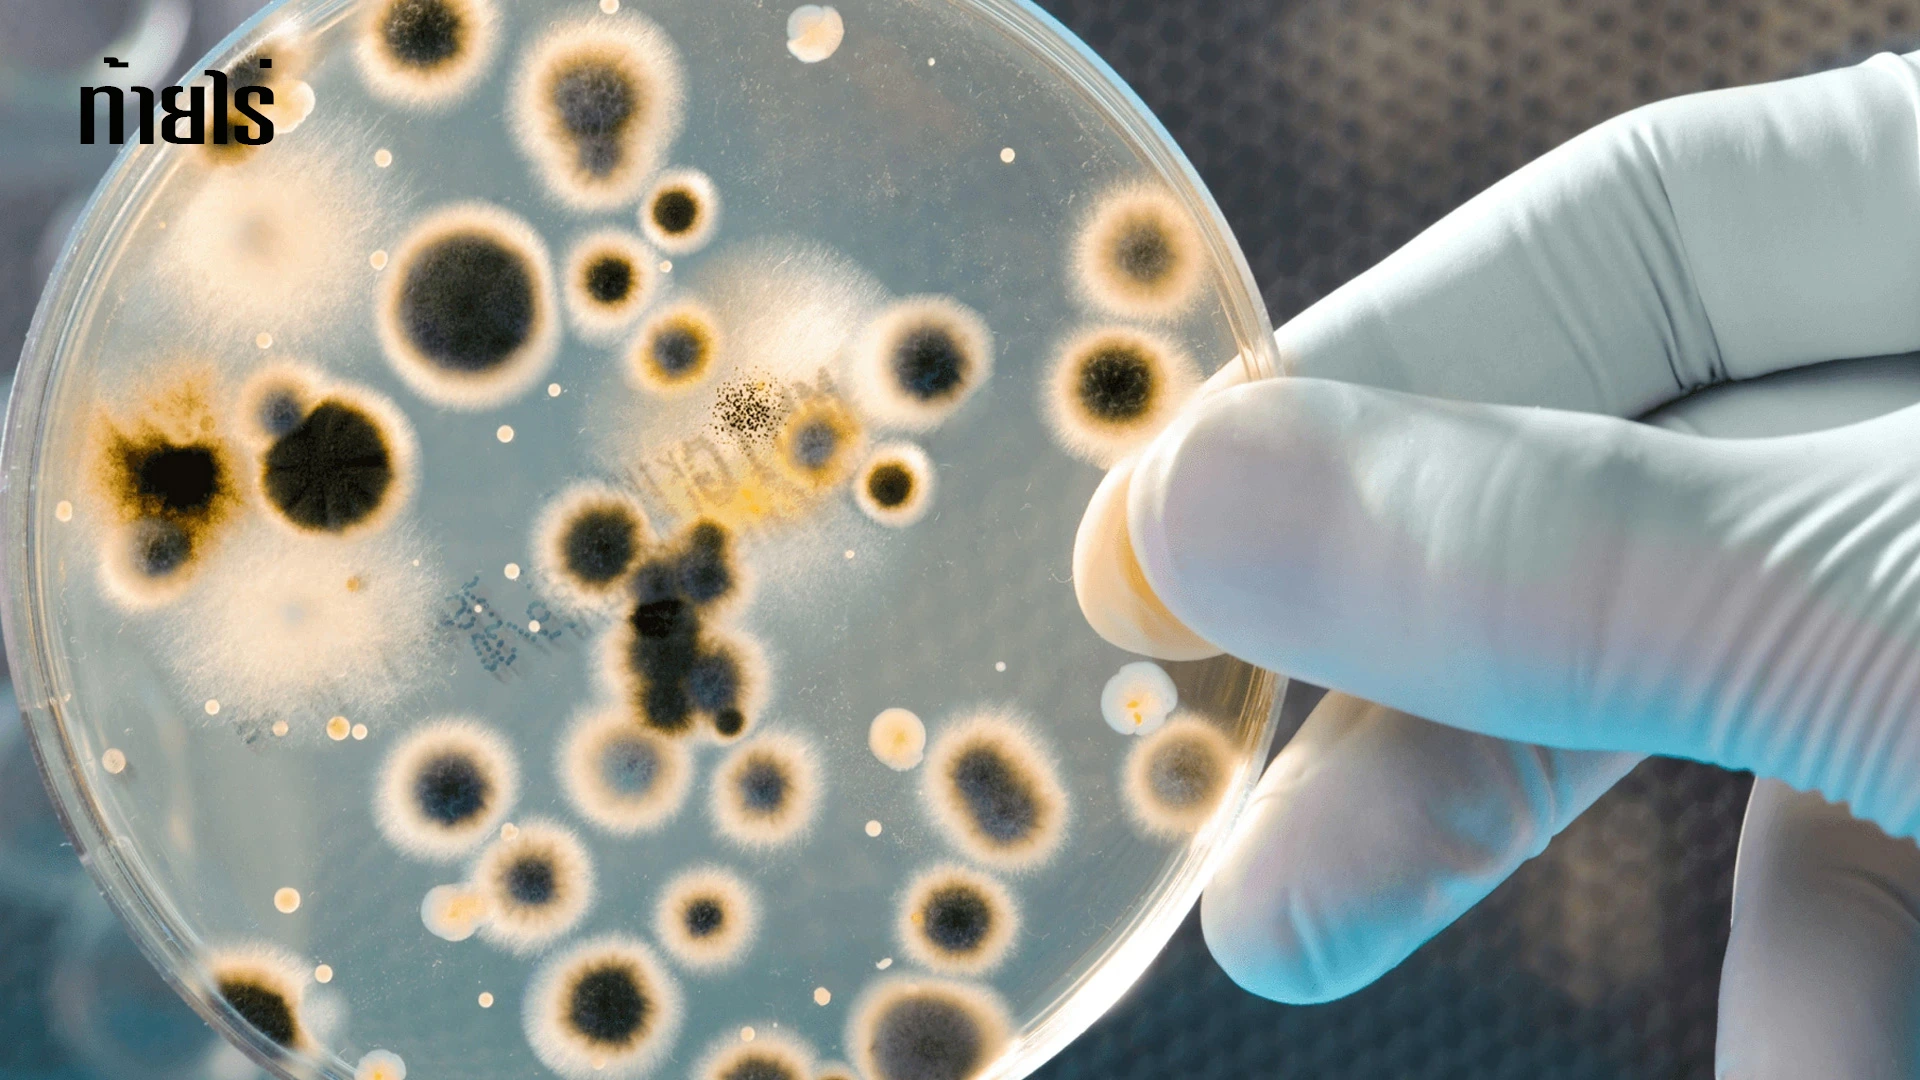

สวนมะนาวท้ายไร่
สวนมะนาวท้ายไร่ เป็นผู้ผลิตและจำหน่ายพันธุ์มะนาวเพื่อจำหน่ายในประเทศและส่งออกต่างประเทศ อีกทั้งยังเปิดเป็นศูนย์การเรียนรู้ อ่านต่อ...
ติดตามการจัดส่ง
| จ.ส.อ.ณัฐพงศ์ เย็นสมพxxx | RL330273346TH |
| วิชัย วงศ์ศักดิ์ถxxx | RL330273332TH |
| เครือวัลย์ รักทxxx | RL330273329TH |
| ศุภชัย อภิศัยดิ์ภารxxx | RL330273315TH |
| สมศักดิ์ กิจโชคประเสริฐ (อู่ช่างหมี่ ภูวxxx | RL330273301TH |
| นฤมล ยมรับxxx | RL330273292TH |
| ดูทั้งหมด |